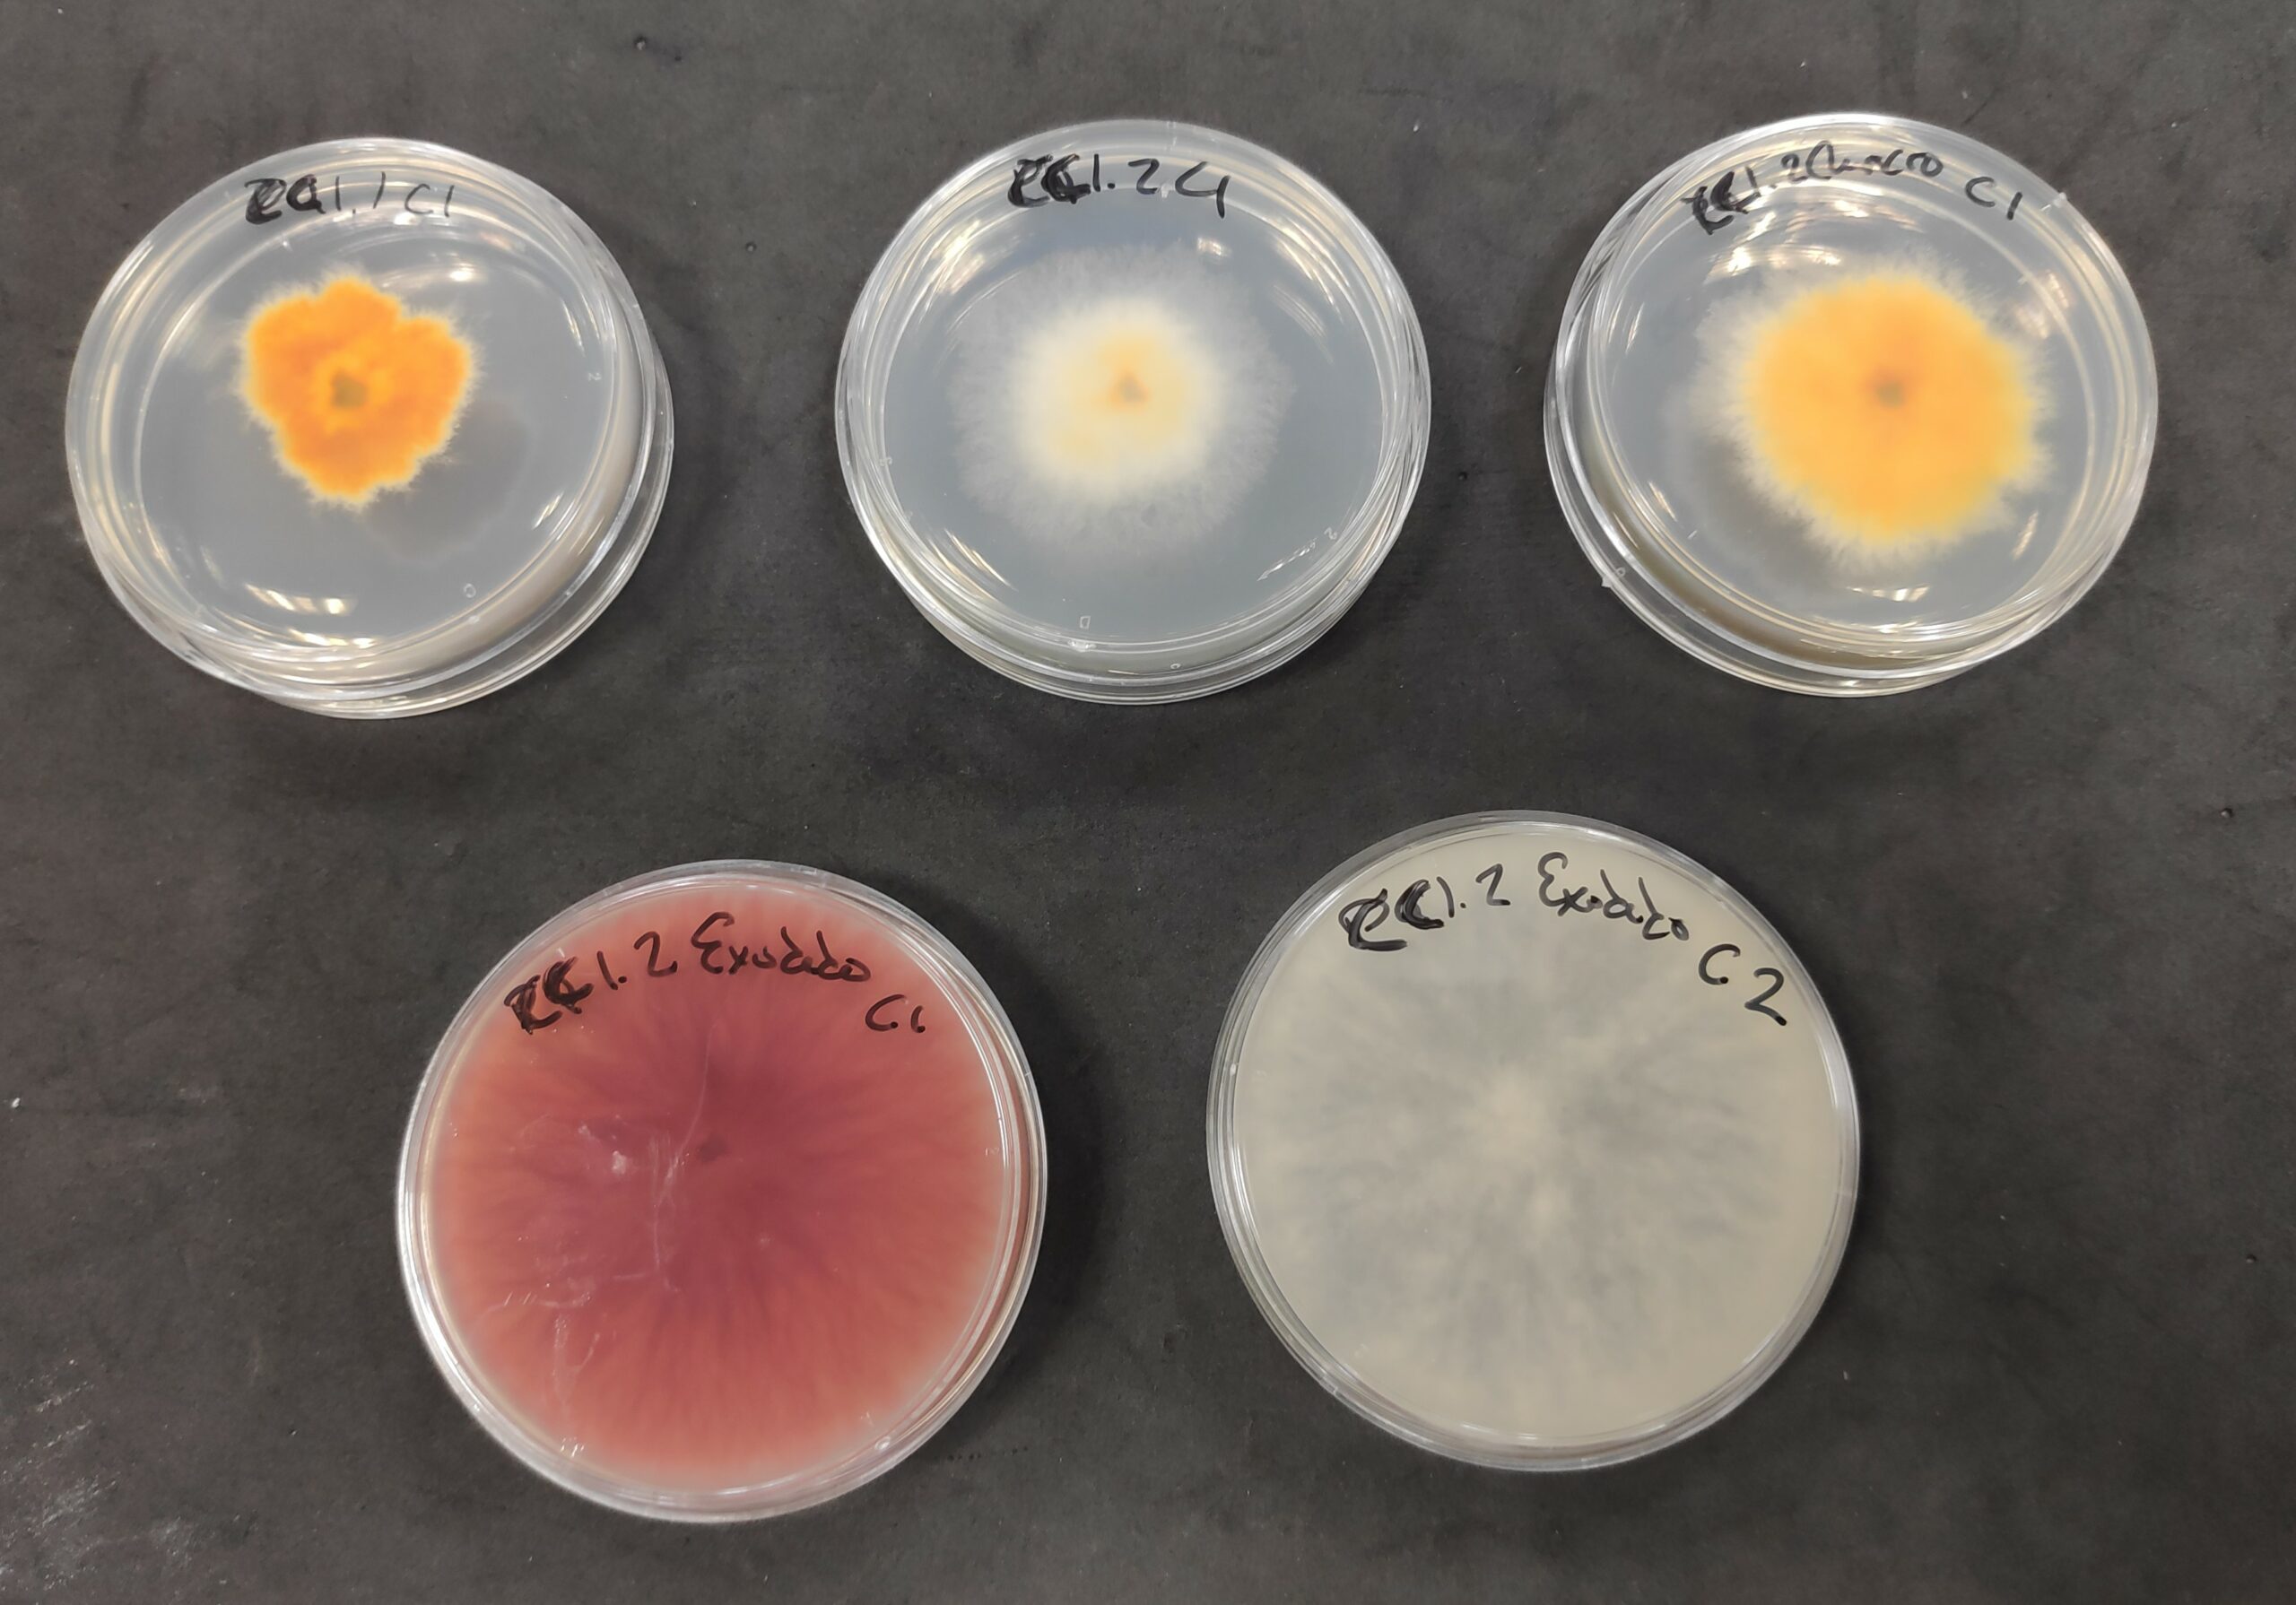
hongos4
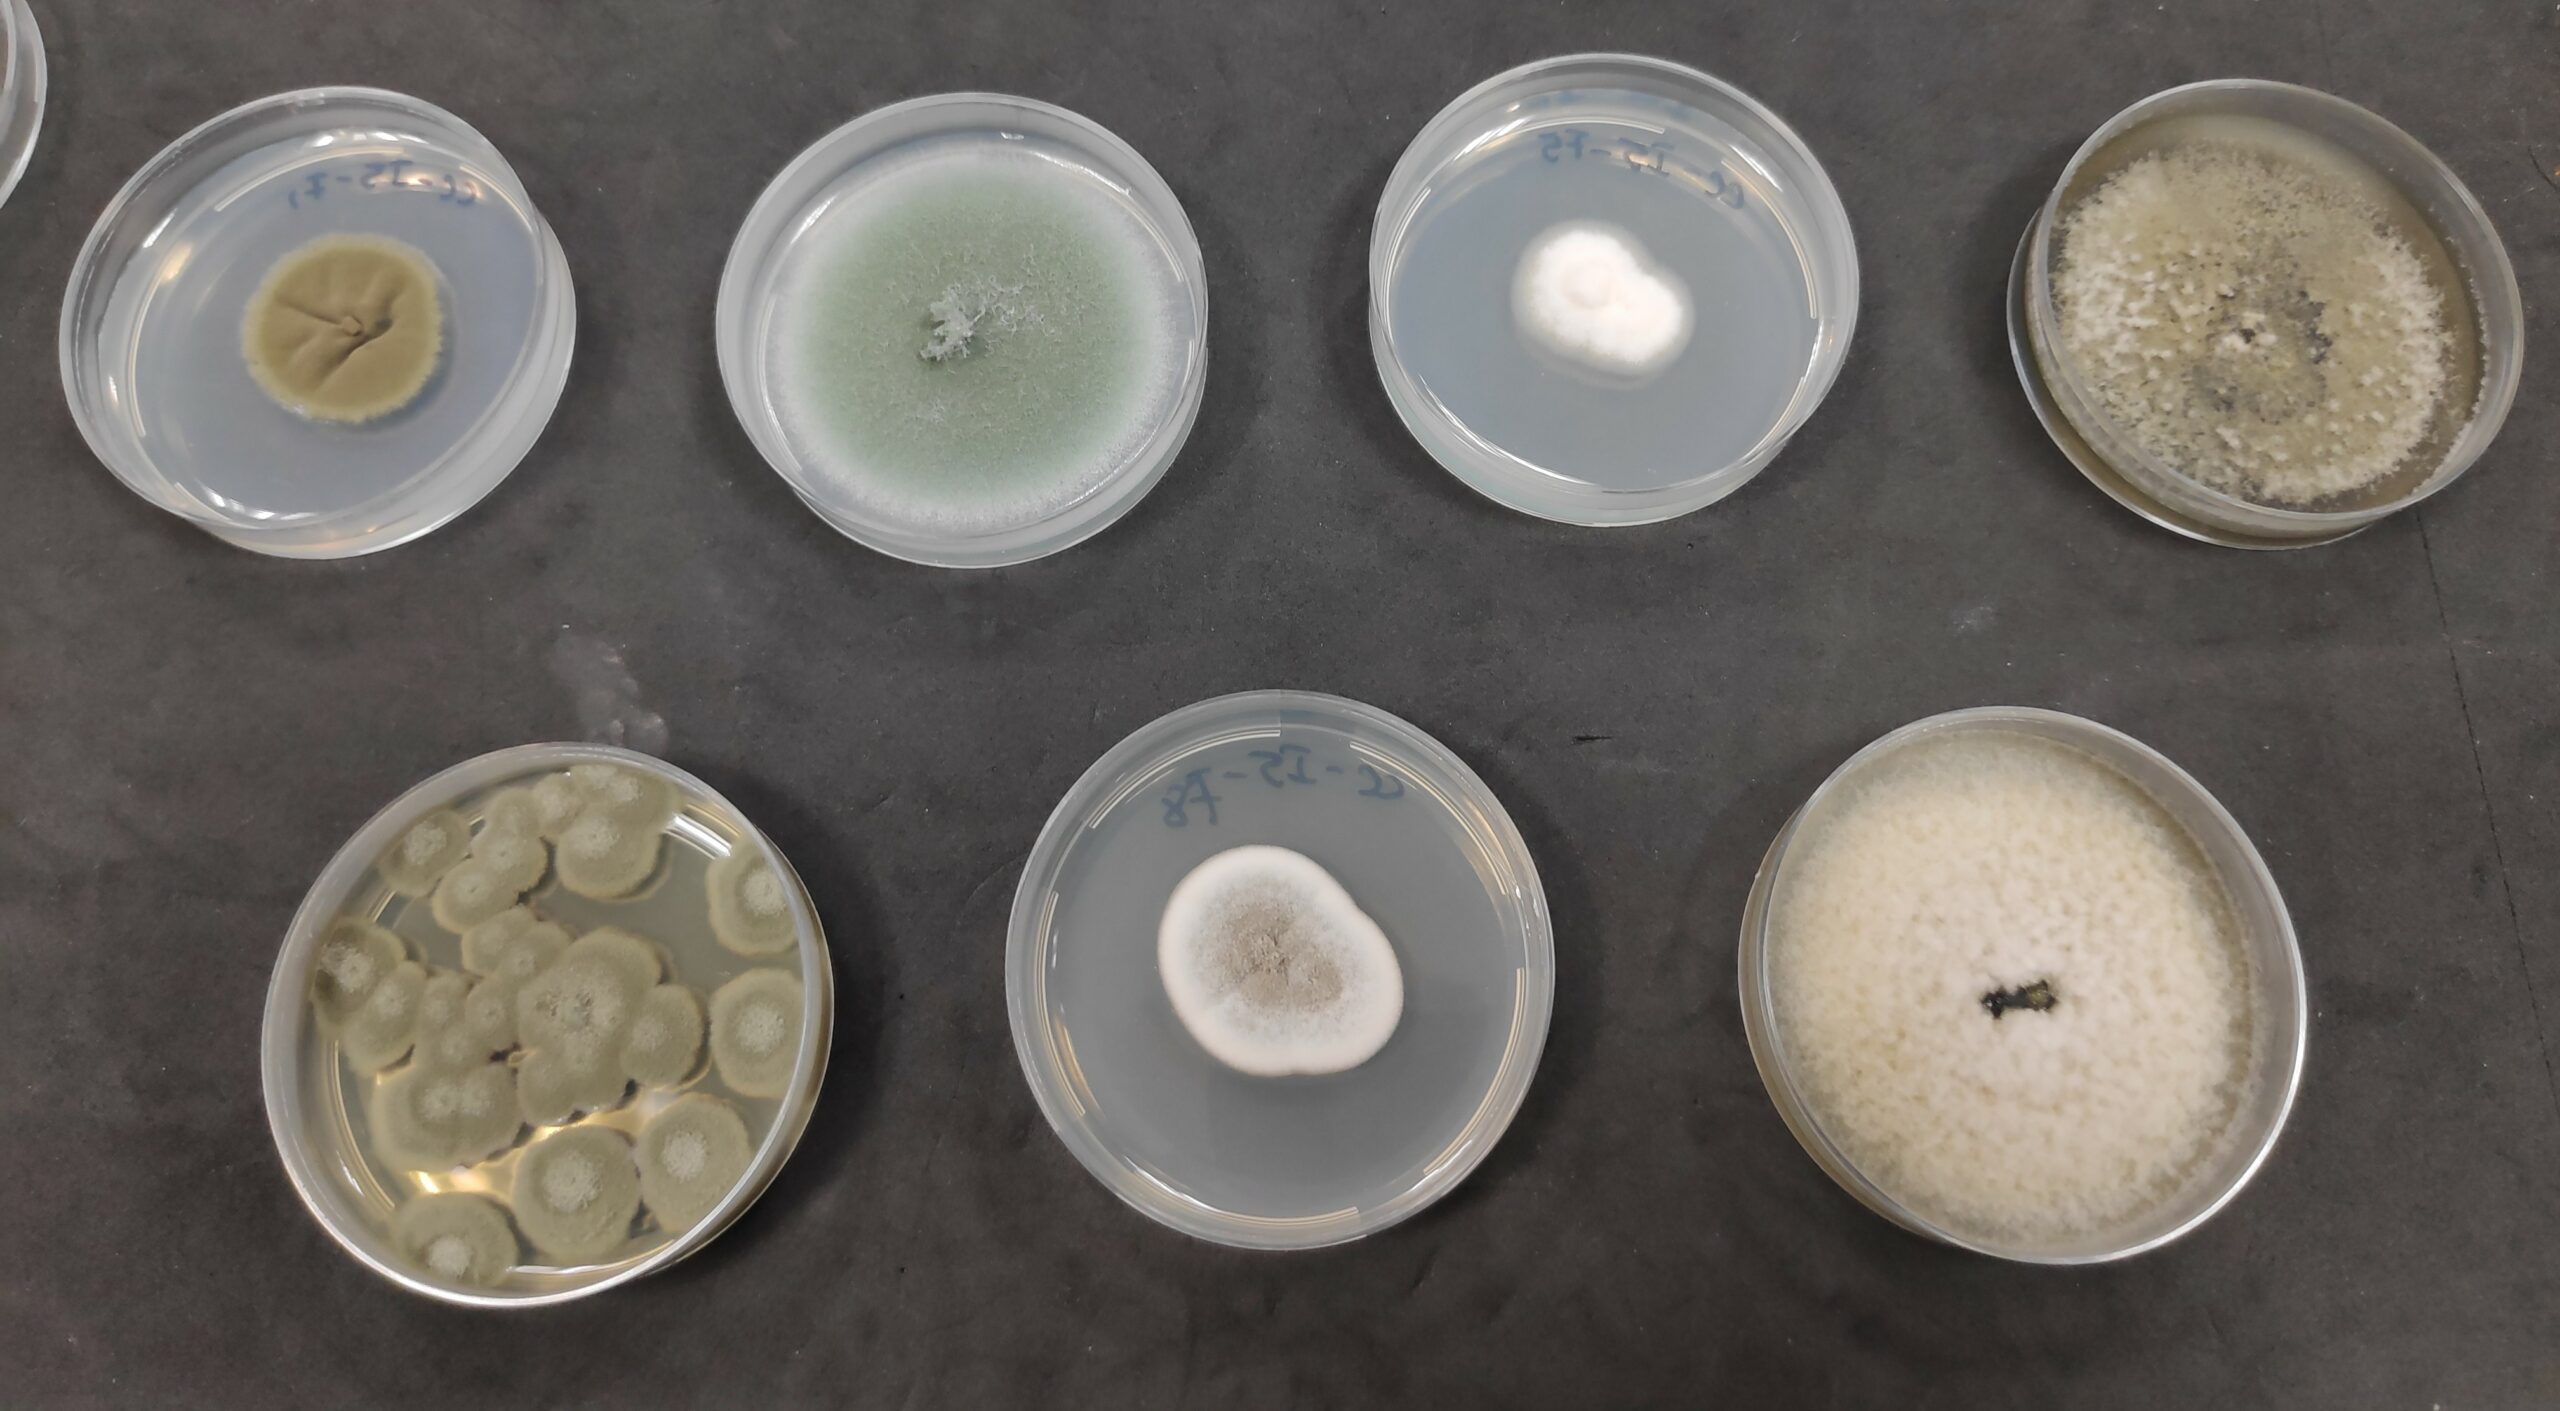
hongos2

Infraestructuras
El iuFOR se esfuerza por facilitar y potenciar la investigación, proporcionando instalaciones especializadas y equipos adecuados para satisfacer las necesidades de nuestras investigadoras e investigadores.
Contamos con sedes en los Campus de Palencia, Soria y Valladolid pertenecientes a la Universidad de Valladolid, además de ser Unidad Asociada al CSIC a través del Instituto de Ciencias Forestales (ICIFOR, INIA) y del Museo Nacional de Ciencias Naturales (MNCN). Esto enriquece muchísimo, no sólo las posibilidades de interacción y colaboración entre científicos, sino también, las infraestructuras y equipamientos que están a disposición de nuestro personal docente e investigador y que permiten el análisis y procesamiento de muestras con diferentes requisitos experimentales. Además, el iuFOR cuenta con una red de estaciones de investigación experimentales que han sido controladas durante años y que ofrecen la oportunidad de estudiar procesos ecológicos, adaptativos o de manejo forestal a largo plazo y en distintas escalas espaciales.
Las infraestructuras y equipos disponibles gracias a la Unidad Asociada al CSIC se pueden consultar en los siguientes enlaces: ICIFOR, INIA y MNCN.
A continuación, se presta especial hincapié a las infraestructuras disponibles en las 3 sedes del iuFOR en Palencia, Soria y Valladolid.
Laboratorios del iuFOR
DendroLab [Laboratorio de Dendrocronología y Modelización Forestal]
Situado en la sede iuFOR de Palencia; dispone de instrumental avanzado para el análisis de datos útiles para el desarrollo de investigación en Selvicultura Cuantitativa.
EQUIPAMIENTO:
- Analizador de imágenes WinDendro
- Cámara fría
- Zona de preparación y lijado de muestras
- Lupa
- Microscopio
- Microtomo
- Estufas de secado
- Cámaras de germinación
RESPONSABLE:
Dr. Felipe Bravo
Catedrático de Universidad
Producción Vegetal
E.T.S. de Ingenierías Agrarias
Avenida de Madrid, 57, 34004
Teléfono/Extensión: 97910-8424
felipe.bravo@uva.es


Laboratorio de Micología Aplicada
Situado en la sede iuFOR de Palencia; cuenta con los instrumentos necesarios para el estudio de los hongos.


RESPONSABLE:
Dr. Juan Andrés Oria de Rueda
Catedrático de Universidad
Área de Botánica
E.T.S. de Ingenierías Agrarias
Avenida de Madrid, 57, 34004
Teléfono/Extensión: 97910-8364
juanandres.oria-rueda@uva.es
Más información: https://catedrademicologia.com/
EQUIPAMIENTO:
- Básculas
- Estufas de secado
- Microscopios
- Lupas binoculares
- Cámara de flujo laminar
- Autoclave
- Cámaras y armario de cultivo
- Frigoríficos
- Medios de cultivo
- Reactivos fúngicos
Laboratorios de Edafología y Química Agrícola
Constituyen unas instalaciones de apoyo a la docencia y a la investigación en ciencias del suelo y química agrícola, situadas en la sede iuFOR de Palencia. Son cuatro laboratorios independientes, uno destinado al pretratamiento de muestras y otros tres a su análisis.
LABORATORIO DE PRETRATAMIENTO DE MUESTRAS:
- Material para muestreos en campo (azadas, palas, picos, sondas o tomamuestras, etc.)
- Mesas para el tratamiento de las muestras
- Tamices de distintos tamaños de luz
- Molino de bolas vibratorio Retsch MM301
- Molino centrífugo Retsch ZM100


RESPONSABLE:
Dra. M. Belén Turrión Nieves
Catedrática de Universidad
Área de Edafología y Química Agrícola
E.T.S. de Ingenierías Agrarias
Avenida de Madrid, 57, 34004
Teléfono/Extensión: 97910-8331
mariabelen.turrion@uva.es
LABORATORIOS DE ANÁLISIS FÍSICOS, QUÍMICOS Y BIOQUÍMICOS:
- Autoanalizador Leco C-H-N 2000
- Analizador TOC/TN Skalar
- Cromatógrafo de gases Perkin Elmer Autosystem XL
- Espectrofotómetro de absorción atómica Variant AA240S
- Espectrofotómetro con cámara de grafito Variant Zeeman
- Equipo de digestión por microondas Milestone ETHOS
- Espectrofotómetro ultravioleta/visible Hitachi U2001
- Equipo para la determinación de pF en suelos Eijkelkamp
- Ultrasonicador para la disgregación de muestras Branson Sonifier 450
- Liofilizador Telstar Cryodos
- Sistema MILLIPORE de producción de agua ultrapura Milli-Q
- Permeámetro de nivel constante para la medida de permeabilidad en suelos
- Cámara de incubación Medilow Selecta para medidas de respiración microbiana
Laboratorio de Cultivo in vitro
Se dedica a la docencia e investigación en técnicas de cultivo in vitro con fines de propagación clonal y conservación de germoplasma. Situado en la sede iuFOR de Palencia.
EQUIPAMIENTO:
- Equipamiento necesario para desarrollar cultivos in vitro de planta forestal
RESPONSABLE:
Dra. Rosario Sierra de Grado
Profesora Titular de Universidad
Producción Vegetal
E.T.S. de Ingenierías Agrarias
Avenida de Madrid, 57, 34004
Teléfono/Extensión: 97910-8418
rsierra@uva.es

Laboratorio de Diagnóstico Genético y Bioinformática
Dotado de equipamiento que permite el análisis genético de plantas y otros organismos de interés forestal. Situado en la sede iuFOR de Palencia.


RESPONSABLE:
Dra. Elena Hidalgo Rodríguez
Profesora Titular de Universidad
Producción Vegetal
E.T.S. de Ingenierías Agrarias
Avenida de Madrid, 57, 34004
Teléfono/Extensión: 97910-8419
mariaelena.hidalgo@uva.es
EQUIPAMIENTO:
-
Analizador de fragmentos de ADN (ABI Prism 310)
- Molinillo RETSCH MM301
-
Termocicladores
-
Homogeneizador de muestras
-
Sistema de cuantificación de AN
-
Tanques de electroforesis horizontal y vertical
- Cuantificador de ADN por espectrofotometría
- PCR a Tiempo Real y cuantitativa
-
Estufa de hibridación
-
Equipos de frío
-
Baños termostatizados
-
Microfugas y Centrífuga refrigerada
-
Speed-Vac
-
Cabina de flujo laminar
-
Autoclave de sobremesa
Laboratorio de Plagas y Enfermedades Forestales
Laboratorio de protección forestal dedicado a la docencia e investigación relacionada con el estudio, control biológico y manejo integrado de hongos e insectos forestales. Situado en la sede iuFOR de Palencia.
EQUIPAMIENTO:
- Campana de extracción
- Ultracongeladores
- Autoclaves
- Microscopios con y sin cámara acoplada
- Microscopio epifluorescente
- Lupas de magnificación
- Baños de ultrasonido
- Medidor de integridad de material genético (Qubit)
- Molino homogeneizador
- Ultracentrífugas
- Microcentrífugas
- Electroporador
- Liofilizador
- Medidor de clorofila
- Cabinas de flujo laminar
- Sistema de electroforesis
- Transiluminadores
- Termocicladores (PCR)
- Agitadores orbitales y térmicos
- Estufa de cultivo
- Extractor de material genético TACO
- Estufa de hibridación
- UV Crosslinker
- Concentrador de muestras Speedvac
- Medidor de pH
- Balanzas
- Fitotrones
RESPONSABLE:
Dr. Julio Díez Casero
Catedrático de Universidad
Patología Forestal
E.T.S. de Ingenierías Agrarias
Avenida de Madrid, 57, 34004
Teléfono/Extensión: 97910-8420
juliojavier.diez@uva.es


LTI: Laboratorio de Técnicas Instrumentales de la UVa
Servicio central de apoyo a la investigación de la Universidad de Valladolid. Tiene su sede principal en el campus de Valladolid y dos pequeñas sedes en los campus de Palencia y de Soria.
Ver más información AQUÍ.
Viveros e Invernaderos
Invernaderos de Producción Vegetal
Tenemos disponibles, tanto para investigación como para docencia, distintos tipos de invernaderos, así como zonas de engorde de planta producida, campos de ensayos, plantación frutal, viñedo…

RESPONSABLES:
Dr. Julio Díez Casero
Catedrático de Universidad
Patología Forestal
E.T.S. de Ingenierías Agrarias
Avenida de Madrid, 57, 34004
Teléfono/Extensión: 97910-8420
juliojavier.diez@uva.es
Evelio Alonso Ganado
Técnico Especialista de Laboratorio (Agraria)
Teléfono/Extensión: 97910-8324
evelio.alonso@uva.es
M. Felicidad López Sáinz
Titulada Superior Agraria
Teléfono/Extensión: 97910-8337
mariafelicidad.lopez@uva.es
M. Aránzazu Otaño LLorente
Titulada Superior Agraria
Teléfono/Extensión: 97910-8337
mariaaranzazu.otano@uva.es
INVERNADERO ADOSADO AL EDIFICIO (1.1):
- Cubierta y cerramiento de cristal reforzado
- Sistema de ventilación cenital neumático + sistema de ventilación lateral manual
- Calefacción de agua caliente a través de tuberías
- Zonas protegidas por mallas de sombreo
- Riego manual con manguera + barra de nebulización automatizada para dos mesas del invernadero
- Cámara de cultivo o fitotrón donde se controla temperatura, humedad y luz
- Dos mesas de cama caliente mediante resistencia eléctrica para mejorar y favorecer el enraizamiento
- 1 mesa de inundación
- 4 mesas pequeñas y 4 grandes con base de tramel
- Mesa de trabajo para prácticas de fibrocemento
- 2 humificadores
INVERNADERO (1.9):
- Invernadero estanco de alta seguridad
- Ver información más abajo
POZOS (3.a y 3.b):
- Con sistema de riego completo (motor, bomba, filtros…)
CASETA DE RIEGO (4):
- Con programador que riega y abona los campos de cultivo (frutales, viñas y campos de ensayo) y todos los invernaderos, excepto el 1.1. que tiene su propio programador.
ZONA DE CÉSPED:
- Con distintos tipos de mezclas de céspedes
INVERNADERO RÍGIDO (1.2):
- Cubierta y cerramiento de policarbonato y metacrilato.
- Barra de riego con nebulizadores programable desde caseta de riego
- Riego manual con manguera y pistola de riego
- Ventilación cenital eléctrica, mediante sonda
- Sin ventilación lateral
- 3 mesas
- 1 mesa de inundación
BITÚNEL (1.3):
- Cubierta flexible de polietileno
- Ventilación lateral mediante enrolle del polietileno
- Sistema de riego mediante ramales con goteros incorporados
TÚNELES (1.4):
- Túneles con cubierta de polietileno
PARCELA DE ENGORDE (2.a, 2.b y 2.c):
- Parcela 2.a: 4 trojes o divisiones separados por pasillos de hormigón. Dos de ellos con mesas y sombreo. Riego manual con manguera. Dedicado a planta enraizada más pequeña.
- Parcela 2.b: Riego manual con manguera. Dedicado a planta enraizada más grande y de mayor contenedor.
- Parcela 2.c: Adosado al invernadero 1.2. Tiene 5 mesas. Riego por aspersión. Se usa para la plante de engorde procedente de las prácticas con estudiantes.
VIÑEDO:
- Una fila con variedades de mesa: Italia, Moscatel de Alejandrina, Alfonso Lavalle, Sultanina
- Tres filas con variedades de vinificación de blancas o tintas: Malvasía, Moscatel grano menudo, Prieto Picudo, Mencía, Albillo, Verdejo, Viura, Tempranillo, Cabernet Sauvignon y Syrah
- Varias filas con variedad Tempranillo
TÚNEL (1.5):
- Invernadero ornamental
- Denominado “huerto jardín”
- Dedicado sólo a visitas
TÚNEL (1.6):
- Construido por ITAGRA
- Tiene un laboratorio con cámara de cultivo
- Con un invernadero anexo
MULTITÚNEL (1.7):
- Cubierta y cerramiento de policarbonato compacto ondulado
- Invernadero de dos capillas
- Sistema automático de ventilación
- Calefactores laterales y manta aluminizada desplazable
TÚNELES (1.8):
- Dos invernaderos sin cubierta
- Se usan para prácticas
PARCELA DE FRUTALES:
- Dos filas con frutales de hueso y frutos secos: melocotonero, nectarino, paraguayo, albaricoque, cerezo, ciruelo, caqui, membrillero, olivo, almendro, nogal y avellano
- Una fila con variedades de manzano: Royal Gala, Fuji, Early Red One, Golden, Reineta gris y Reineta blanca
- Una fila con variedades de peral: Harrow Sweet, Eliot, Abate, Conferencia, Williams, Carmen y Blanquilla
PARCELA DE ENSAYO DE EXTENSIVOS:
- Trigos, cebadas, centenos…
ZONA DE COMPOSTAJE Y QUEMA:
- Un troje para almacenar los restos de poda, para posteriormente quemar
- Dos trojes para almacenar restos de cosechas que se van compostando para usar en los invernaderos
Invernadero de Seguridad Biológica de Nivel de Contención 2 (NCB2)
Esta instalación está compartimentada en cabinas independientes, automatizada para el control climático y dotado de todos los elementos necesarios para el cultivo. Además, cuenta con los equipamientos necesarios para llevar a cabo labores experimentales con un nivel de contención biológica adecuada, minimizando el riesgo biológico.
Sirve para el desarrollo de diversas actividades investigadoras como ensayos de patogenicidad y resistencia de cultivos y especies forestales frente a patógenos de cuarentena, manejo de patógenos y agentes biológicos de cuarentena (bacterias, hongos, oomicetos y nematodos) que afectan a sistemas agroforestales, evaluación de eficacia de métodos de control y biocontrol de patógenos, efecto del cambio climático sobre especies agrícolas y forestales, etc.
Estas instalaciones dan respuesta a las necesidades de diferentes grupos de investigación de la Universidad de Valladolid, así como a grupos de otras universidades relacionados con la sanidad vegetal, mejora genética vegetal y fitopatología.
EQUIPAMIENTO:
- Cabinas independientes
- Sistema de calefacción
- Aire acondicionado
- Filtración HEPA
- Sombreado
- Iluminación artificial
- Mesas de cultivo
- Sistema de riego automatizado
- Sistema de recogida de agua de drenaje
- Sistema Biowaste para descontaminación de las aguas de riego
- Esclusa de entrada con presión positiva
- Control de acceso
RESPONSABLE:
Dr. Julio Díez Casero
Catedrático de Universidad
Patología Forestal
E.T.S. de Ingenierías Agrarias
Avenida de Madrid, 57, 34004
Teléfono/Extensión: 97910-8420
juliojavier.diez@uva.es


Colecciones
Cores
Loading…


Monolitos edafológicos
El Grupo de Investigación Reconocida (GIR): SQS Suelos, Calidad y Sostenibilidad del iuFOR está creando una colección de monolitos edafológicos de distintos suelos de la provincia de Palencia.
Un monolito es un bloque de suelo extraído con el menor grado de alteración posible y alcanzando la profundidad total del perfil de suelo que proporciona información esencial sobre las propiedades morfológicas del suelo, como color, textura, estructura, actividad biológica y más. Estos monolitos hacen visibles y comprensibles conceptos sobre suelos que, de otra manera, no podríamos observar directamente.
Esta colección trata de dar apoyo docente en las asignaturas relacionadas con el estudio del suelo, además de servir como herramientas de educación, sensibilización y divulgación científica a la sociedad en general.
Actualmente la colección está formada por un perfil de suelo antrópico y tres suelos naturales de distintas características y diferentes zonas palentinas; pero se irá ampliando para cubrir todos los distintos tipos de suelo de las provincias de Palencia y Valladolid, al menos. Los monolitos están expuestos en la E.T.S. de Ingenierías Agrarias e incluyen una explicación del tipo de suelo, sus horizontes y profundidades, sus propiedades, la zona de extracción, etc.
Hongos forestales
Desde el año 1990 la colección de hongos forestales recogidos por miembros de IUFOR en la ETSIIAA ha superado las 3600 muestras de especies de interés. Los trabajos científicos de campo han resultado el origen de la llegada de este material. Destacan las colecciones de hongos micorrícicos de los géneros Pisolithus, Scleroderma, Astraeus, Hydnum, Tuber, Terfezia, Suillus, Boletus, etc que se conservan secos. También existe una colección de carpóforos liofilizados que están expuestos en una colección de vitrinas en el Edificio Principal de la ETSIIAA. La ubicación es en la primera planta del Edificio Principal de la ETSIIAA, así como en los laboratorios de Fisiología y Botánica Forestal.
También destaca la colección de plantas de Botánica forestal, con más de 2500 muestras de géneros de especial importancia forestal (Populus, Salix, Quercus, Rhamnus, etc) así como de herbáceas acuáticas, arvenses, etc, dentro del Herbario del área de Botánica Palencia (PALAB). La ubicación es en el espacio conocido como Herbario del Edificio Principal de la ETSIIAA, así como en varios espacios en los laboratorios de Biología, Fisiología y Botánica Forestal.

Colección de hongos (investigación)
- Patógenos forestales:
- Fusarium circinatum
- Cryphonectria parasítica
- Phytophthora plurivora, P. alni, P. cinnamomi, P. cambivora, P. parvispora
- Botrytis cinérea
- Ophiostoma minus
- Heterobasidion annosum
- Fusarium oxysporum
- Gremeniella abietina
- Alternaria sp.
- Endófitos:
- de pino
- de encina
- de castaño
- Trichoderma sp.
- Entomopatógenos:
- Beauveria bassiana
- Beauveria pseudobassiana
Colección de plagas (docencia)
- Plagas de Coníferas:
- Defoliadores y perforadores de yemas y brotes.
- Perforadores de troncos y piñas; Chupadores.
- Plagas de Fagáceas:
- Defoliadores de los Quercus
- Perforadores y chupadores de Quercus
- Plagas de Fagus y Castanea
- Plagas de Salicáceas: Defoliadores, perforadores y chupadores de Populus y Salix
- Fanerógamas parásitas, Nemátodos fitoparásitos, Bacteriosis y Virosis
- Plagas y enfermedades de viveros forestales.
- Enfermedades de Pinus.
- Enfermedades de otras gimnospermas.
- Enfermedades de Quercus.
- Enfermedades de Castanea.
- Enfermedades de Fagus.
- Enfermedades de Populus.
- Enfermedades de Salix.
- Plagas y enfermedades de Ulmus.
- Plagas y enfermedades de Eucalyptus.
- Plagas y enfermedades de otras frondosas.
- Pudriciones y alteraciones de la madera.
Plagas forestales: estudio y la lucha contra insectos-plaga invasores a través de diferentes técnicas de manejo integrado. El grupo es especialista en la cría de Leptoglossus occidentalis, conocida como la chinche americana del pino, de la cual tenemos una población estable en el laboratorio. Esta chinche es un grave problema en las plantaciones de piñones, disminuyendo hasta en un 80% las producciones de piñón y dificultando la regeneración natural de las zonas de pinar.
En el laboratorio de plagas se han desarrollado numerosos avances en torno al control del nemátodo del pino, Bursaphelenchus xylophilus. Este nemátodo es un organismo nocivo que provoca graves daños en las especies del género Pinus sp. y otras coníferas. Su ataque causa el decaimiento súbito de los árboles afectados, produciendo una sintomatología conocida como “seca o marchitamiento de los pinos”.
Enfermedades forestales: diagnóstico y control de diversas patologías de chopos, castaños, pinos y robles causadas por hongos y virus, así como la utilización de métodos de control inocuos para el medioambiente, como el control biológico mediante la utilización de hongos endófitos y RNA interferente.
El grupo también se dedica al estudio de micovirus de agentes fúngicos. se llevan a cabo experimentos destinados a erradicar enfermedades forestales, en concreto, la seca de la encina agravada por el oomiceto Phytophthora y los chancros del pino y el castaño, este último provocado por Chryphonectria parasitica.
Softwares
SERVIDOR DE PROCESOS (supercomputador)
En el iuFOR tenemos disponible un equipo de alto rendimiento con capacidades de cálculo superiores a los comunes, capaz de realizar tareas que no puede realizar un ordenador convencional, ya que cuentan con numerosos procesadores y con una gran memoria. Este equipo se encuentra a disposición de todos los miembros del iuFOR que lo necesiten y soliciten para sus investigaciones. A nivel técnico, el sistema operativo es Alma Linux que viene de una migración de CentOS. El acceso al servidor se realiza mediante el protocolo SSH Secure Shell que sirve para el acceso a máquinas remotas a través de una red. Permite el trabajo remoto a través de un intérprete de comandos, aunque también permite redirigir el tráfico de los programas gráficos del equipo remoto hacia la pantalla del equipo local.
En el ámbito forestal los supercomputadores hacen posibles modelos mucho más precisos en tareas intensivas. Por ejemplo, permiten el ajuste de modelos de datos forestales en condiciones de cambio climático global y predicciones meteorológicas regionales con más días de antelación. También permiten simular y proyectar diferentes condiciones del rodal (mediante algoritmos y fórmulas de predicción y proyección), sistemas de consultas, salidas de simulaciones, etc. Se utilizan en medición geoespacial ya que permite obtener datos topográficos precisos para elaborar mapas y modelos de terreno.
Un uso concreto del Servidor de Procesos por parte de miembros del iuFOR ha sido procesar las nubes de puntos adquiridas por el escáner laser móvil (LiDAR) en bosques mixtos mediante la aplicación en Python Forest Structural Complexity Tool (FSCT). Esta herramienta extrae automáticamente las medidas a escala de rodal de las nubes de puntos forestales de alta resolución. El procesamiento de datos de alta resolución suele ser un factor limitante desde el punto de vista computacional, lo que hace que la mayoría de los investigadores reduzcan la cantidad/calidad de los puntos para hacerlos viables. El uso del superordenador permite aprovechar todo el potencial del escáner láser móvil. Además de las nubes de puntos escaneadas en Jarandilla de la Vera en diferentes épocas del año, también se han procesado los datos obtenidos con el Escáner Láser Terrestre en Alemania, Marugán, Valdepoza y Palencia.
Se trata de una hoja de cálculo que permite simular la evolución de rodales de pino silvestre en la cuenca del Alto Ebro (norte de España).
Descarga el simulador AQUÍ
Este paquete de R establece un nuevo enfoque para incorporar variables dinámicas de biomasa arbórea en estudios dendrocronológicos. Se desarrolló un algoritmo multinivel para modelar el crecimiento de la biomasa a partir de cronologías de anillos de árboles y para establecer relaciones temporales entre la dinámica de la biomasa y la sequía.
Más información en: CRAN y GitHub
Paquete de R para detectar y medir anillos de crecimiento en imágenes escaneadas de núcleos dendrocronológicos. Integra la medición de anillos de crecimiento con el poder estadístico del R. Los algoritmos calculan reflectancias a partir de secciones de imágenes produciendo matrices de gris (MG) y sus correspondientes series promedias suavizadas (SPS).
Más información en: CRAN y en este artículo científico. Puedes ver un ejemplo de uso AQUÍ
‘measuRing’ en los medios de comunicación: La Vanguardia / ABC / El Norte de Castilla / El Confidencial / El Mundo de Castilla y León
Aplicación web que permite simular alternativas de gestión forestal sostenible. Integra diferentes módulos para manejar inventarios forestales, simular y proyectar diferentes condiciones del rodal (mediante algoritmos y fórmulas de predicción y proyección), sistemas de consultas, salidas de simulaciones y sistema de seguridad.
Más información y software AQUÍ
Herramienta informática libre destinada a la gestión de Aulas de Señalamiento Forestal. Sus principales objetivos son facilitar la toma de decisiones en el señalamiento forestal y servir de apoyo a la enseñanza en este campo mediante la organización y tratamiento de datos forestales, la evaluación de diferentes escenarios y alternativas, así como la obtención de resultados numéricos y gráficos de naturaleza dendrométrica, económica y ecológica. Existe una APP para Android y una versión para ordenador en la web de SIMANFOR.
Más información del proyecto y de la herramienta (PDF/presentación/póster). Caso práctico con Smartelo.
Este paquete de R permite manejar con flexibilidad y potencia las bases de datos existentes del lnventario Forestal Nacional de España (IFN) para desarrollar investigación forestal. También se puede utilizar con fines de gestión y planificación al permitir el cálculo de existencias, densidad, estructura forestal, composición específica, etc., en una región geográfica definida por el usuario.
Este modelo semiempírico simula, a lo largo de un día, la fijación de carbono y la acumulación de biomasa para plantines forestales (brinzales) de cualquier especie. El modelo tiene como objetivo servir como herramienta para la docencia universitaria en el ámbito forestla y biológico, permitiendo simular la disponibilidad de recursos, la fijación de carbono y el crecimiento total de un brinzal bajo distintos escenarios silvícolas y ambientales.
Más información: AQUÍ
El proyecto RS-educA© ha sido desarrollado para servir de apoyo y herramienta en el ámbito de la formación en teledetección. RS-educA© tiene tres componentes: 1) el programa informático RS-educA©, 2) los materiales educativos elaborados para el entorno RS-educA©, y 3) la plataforma educativa RS-educA©. El proyecto globalmente integrado en la idea de la innovación educativa está siendo utilizado en las universidad de Valladolid y León.
Más información y descarga de software: AQUÍ
Página web que contiene recursos para profesionales, responsables de políticas, administraciones forestales, asociaciones de propietarios de bosques y otros interesados. A través de este sitio web se puede: (1) buscar en la biblioteca SIMWOOD de soluciones de movilización de madera, (2) revisar los recursos disponibles en Europa, (3) leer noticias sobre la movilización de la madera y (4) cargar un proyecto.
Loading…
Patentes
El conocimiento derivado de nuestras investigaciones debe llegar a los usuarios finales (gestores, políticos y población en general) para que de esta manera la gestión forestal tenga una base científica que acompañe a las dimensiones sociales y económicas. Por ello, desde el iuFOR estamos implicados en el desarrollo de productos y servicios que sirvan para transmitir los resultados de nuestra investigación.
Mediante este catálogo de patentes y servicios pretendemos mostrar una parte de lo que ofrecemos a entidades, empresas o instituciones que lleven a cabo actividades relacionadas con el medio ambiente.
¡Si tienes cualquier duda o no encuentras lo que buscas pero crees que podemos ayudarte, no dudes en contactar con nosotros!
Galloprotect 2d
Cebo para atraer a trampas, donde sea capturado y controlado, al insecto perforador del pino Monochamus galloprovincialis, actual transmisor en Europa del nematodo del pino (Bursaphelenchus xylophilus), patógeno causante de la enfermedad del marchitamiento de los pinos.
Ha sido patentado por la Universidad de Valladolid en España (P200930883) y en Europa (10824500.2.-1454). La patente es válida en Alemania, Austria, Bélgica, España, Francia, Italia, Portugal, Noruega, Suecia y Reino Unido. Más información y adquisición, AQUÍ.

Dendroflexómetro
El DendroFlexómetro© es un instrumento para medir las principales variables dimensionales de un árbol y de una masa forestal.
Sus ventajas se basan en que combina distintas técnicas clásicas de medición forestal (muestreo angular, bastón de Biltmore, regla de Christen, etc.), posibilita que las mediciones las pueda realizar un único operario y es económico.
La explotación comercial del DendroFlexómetro© está protegida por patente de la Universidad de Valladolid (P200100767). Más información y adquisición, AQUÍ.

forestéreo
Dispositivo de medición que permite la captación de imágenes estereoscópicas hemisféricas con las que se puede determinar la posición en 3D de los elementos identificados en las imágenes, permitiendo así la medición de distancias, diámetros y alturas de árboles. Se acompaña del software de análisis de imágenes ForeStereo que permite la medición y restitución en 3D de los árboles en un radio de 8 m a partir de las imágenes tomadas, así como la estimación del área basimétrica y el volumen de la masa forestal.
Patentado por el INIA-CIFOR (Unidad Asociada iuFOR) con número de Modelo de Utilidad: MU2005-01738. Más información y adquisición, AQUÍ.

Acceso abierto

El Acceso Abierto impulsa la excelencia en el ámbito académico, la investigación y la construcción del conocimiento, al tiempo que garantiza un flujo ininterrumpido de información.
El iuFOR promueve la difusión de sus resultados de investigación a través de la publicación en acceso abierto de muchas de sus bases de datos, libros y/o manuales y artículos científicos, así como de los TFMs y Tesis Doctorales realizadas en el iuFOR y que se encuentran en el repositorio UVaDOC.
De este modo, brindamos un acceso permanente, gratuito y sin restricciones a nuestros contenidos científicos con el propósito de fomentar la accesibilidad, la visibilidad y el impacto de nuestra investigación.
El Repositorio documental de la Universidad de Valladolid (UVaDOC) se adhiere a las directrices europeas y ofrece, en acceso abierto y a texto completo los documentos de carácter científico, docente e institucional generados por la Universidad de Valladolid.

Plataforma de acceso abierto para compartir, preservar y citar datos y otros productos científicos, contribuyendo a la transparencia, difusión, intercambio de resultados de investigación y reutilización de datos científicos.
Se pueden depositar, compartir y preservar software, conjuntos de datos, publicaciones, presentaciones y cualquier material científico en formato digital a largo plazo.
Busca “iuFOR“ o directamente a nuestros científicos/as y encontrarás publicaciones científicas, bases de datos, software y otros materiales de acceso abierto elaborados por nosotros.
La Universidad de Valladolid, a través del iuFOR, y la Consejería de Medio Ambiente, Vivienda y Ordenación del Territorio de la Junta de Castilla y León presentan el documento:
“Adaptación al cambio climático. Directrices para la adaptación de la gestión del patrimonio natural y la política forestal al cambio climático en Castilla y León”
Este libro busca dar fe de la situación actual y de la evolución más probable de los bosques de CyL, y proponer estrategias de gestión y planificación forestal de forma que se facilite la adaptación de nuestros bosques a las previsibles situaciones futuras.
iuFORdata que es una herramienta gratuita centrada en el manejo de datos de interés para la gestión de los recursos del medio natural y los ecosistemas forestales.
Además, sirve de centro de recursos para los estudiantes y profesores del Máster en Gestión Forestal basada en Ciencia de Datos (DATAFOREST).













